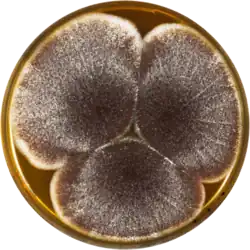

Aspergillus aculeatinus
Taxonavigation
| Taxonavigation: Eurotiales |
|---|
|
Superregnum: Eukaryota |
Familia: Aspergillaceae
Genus: Aspergillus
Species:
Name
Aspergillus aculeatinus Noonim, Frisvad, Varga & Samson, 2008
References
- Akbar, A.; Magan, N. 2014: The impact of water and temperature interactions on lag phase, growth and potential ochratoxin A production by two new species, Aspergillus aculeatinus and A. sclerotiicarbonarius, on a green coffee-based medium. International journal of food microbiology, 188: 116–121. DOI: 10.1016/j.ijfoodmicro.2014.07.025 Reference page.
- Noonim, P. et al. 2008: Two novel species of Aspergillus section Nigri from Thai coffee beans. International journal of systematic and evolutionary microbiology 58(7): 1727–1734. DOI: 10.1099/ijs.0.65694-0 Reference page.